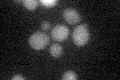
YOR192C
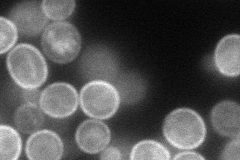
YOR192C
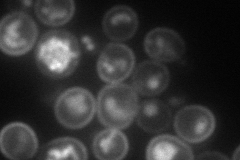
YOR192C
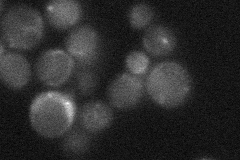
YOR192C
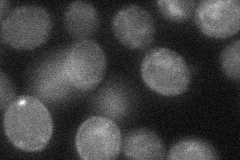
YOR192C
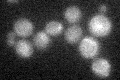
YOR192C

View description
Transporter of thiamine or related compound; shares sequence similarity with Thi7p
Localization:
Intensity:
Fold change:
Significance:
-
C’ GFP library in SD
below threshold18.28 -
N' NOP1pr-GFP in SD
cell periphery,ER,vacuole91.0995 -
N' TEF2pr-mCherry in SD
cell periphery,vacuole81.4413 -
N' NATIVEpr-GFP in SD
vacuole membrane19.0052 -
N' TEF2pr-VC and Cyto-VN in SD
cell periphery,punctate32.6101 -
C’ GFP library in SD+DTT

cytosol13.620.74No -
C’ GFP library in SD+H2O2
cytosol15.590.85No -
C’ GFP library in Starvation Media

cytosol16.770.91No -
C’ GFP library on the background of Pup2-DaMP

below threshold -
C’ GFP library on the background of CCT mutant

below threshold15.86340.867559No
